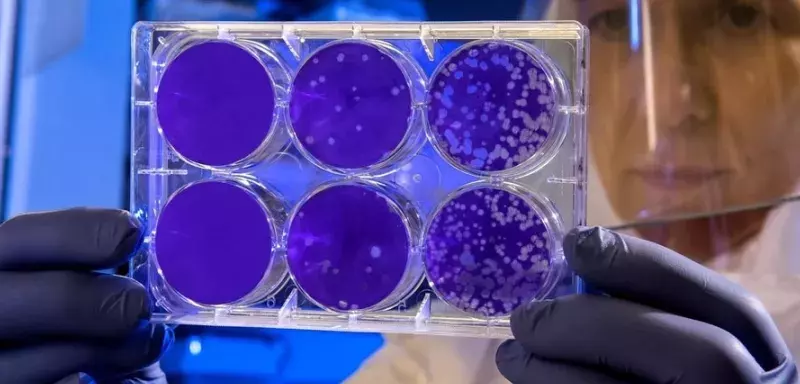
Le coronavirus inventé par un laboratoire français ? Buzz ou réalité ? La pandémie serait-elle provoquée par des laboratoires en quête de profits ?

Buzz ou réalité? Le coronavirus aurait été volontairement crée par un laboratoire français à Wuhan
Depuis quelques heures, une vidéo est très rapidement devenue virale sur les réseaux sociaux. Cette hypothèse (complotiste) selon certains spécialistes refait surface aujourd'hui suite à la diffusiion d'une vidéo d'un dénommé Z4YREX (pseudo) dans laquelle il explique comment un laboratoire français a inventé le virus COVID-19, à l’origine de la pandémie mondiale actuelle. Toute son argumentation repose sur un document officiel disponible en téléchargement sur ce lien . Le document mis en avant étant un brevet déposé en 2003 sous le numéro EP 1 694 829 B1.
Un laboratoire P4 a été créé par la france, en collaboration avec la Chine dans la ville de Wuhan (point de départ de la pandémie mondiale). Ce laboratoire de type P4 abriterait les virus les plus dangereux au monde. Il serait le point de départ de la pandémie actuelle.
Inauguration du laboratoire en le 23 février 2017
Sur le site officiel du gouvernement français, on peut toujours retrouver le discours de bernard Cazeneuve.. Dans le document intitulé : Discours de M. Bernard CAZENEUVE, Premier ministre à la cérémonie d’accréditation du laboratoire de haute sécurité biologique P4 Wuhan, 23 février 2017,on peut lire
Whuhan est une ville ouverte à la science et à la technologie. J'ai visité ce matin le premier laboratoire de haute sécurité biologique en Asie, de classe "P4", dont la maîtrise d'ouvrage avait été confiée à des sociétés françaises. Cette réalisation résulte de notre accord intergouvernemental de 2004 pour la lutte contre les maladies infectieuses émergentes. Votre ville se trouve ainsi doté d'un équipement scientifique de très haut niveau, comme il en existe peu ailleurs dans le monde.
L’intégralité du discour est accéssible sur ce lien
L’auteur de la vidéo (Z4YREX) souligne que M. Yves LEVY le Président-Directeur général de l’INSERM de l’époque mais aussi mari d’Agnès Buzyn, ancienne ministre de la santé. Celle-ci est à l’origine de la polémique, il y a quelque jour, sur le maintien des élections malgré l’urgence et la gravité de la situation.
« Je savais que la vague du tsunami était devant nous. » « Le 30 janvier, j’ai averti [le premier ministre] Edouard Philippe que les élections ne pourraient sans doute pas se tenir. » « On aurait dû tout arrêter, c’était une mascarade. »
Propos recueillis par le journal Le monde ( https://www.lemonde.fr/politique/article/2020/03/18/coronavirus-la-confession-d-agnes-buzyn-suscite-une-double-polemique_6033469_823448.html )
Selon l’auteur de la vidéo, les français ne pouvaient pas ignorer la gravité de la situation puisque la pandémie a commencé dans la ville de Wuhan, et la raison serait la fuite d’un des animaux utilisés pour les tests.
Un brevet (EP 1694 829B1) prouvant que la France est à l’origine de la création du virus
Sur le site officiel répertoriant les brevets vous pouvez facilement retrouver le document mentionné par l’auteur de la vidéo. Il vous suffit de rechercher EP 1694 829B1 sur n’importe quel moteur et vous trouverez ce document de 320 pages.
Il est aussi accessible sur lien : NOUVELLE SOUCHE DE CORONAVIRUS ASSOCIE AU SRAS ET SES APPLICATIONS. - European Patent Office - EP 1694829 B1
L’auteur met en avant certains points que l’on peut facilement retrouver dans le document.
- Les inventeurs qui apparaissent clairement en première page
- L'alinéa 001 sur la page 3:
- La présente invention est relative à une nouvelle souche de coronavirus associé au syndrome respiratoire aigu sévère (SRAS), issue d'un prélèvement répertorié sous le n° 031589 et prélevé à Hanoi (Vietnam), à des molécules d'acide nucléique issues de son génome, aux protéines et peptides codés par lesdites molécules d'acide nucléique ainsi qu'à leurs applications, notamment en tant que réactifs de diagnostic et/ou comme vaccin. - l'alinéa 0012 et 0013 (toujours page 3) : il est mentionné la date de l’apparition du virus actuel.
- 0026 page 5 du brevet est reprise par l’auteur de la vidéo
- page 7, point 35, on peut y lire :
- le plasmide, dénommé SARS-S2, compris dans la souche bactérienne déposée sous le n° I-3019, le 12 mai 2003, auprès de la Collection Nationale de Cultures de Microorganismes, 25 rue du Docteur Roux, 75724 Paris Cedex 15 ; il contient un fragment 3’de la séquence d’ADNc codant pour la protéine S de la souche de SARS-CoV issue du prélèvement répertorié sous le n° 031589, telle que définie ci-dessus, lequel fragment correspondant aux nucléotides des positions 23322 à 25348 (SEQ ID NO :6), en référence à la séquence Genbank n° d’accès AY274119.3
Z4YREX met l'accent sur le fait que des tests ont été effectués avec succès sur des groupes de souris. Il s’appuie sur ce qui est indiqué en page 21 :
- Des groupes de 7 souris BALB/c ont été immunisés à deux reprises à 4 semaines d’intervalle à l’aide de 50 Pg d’ADN plasmidique de pCI, pcDNA-S, pCI-S, pcDNA-N et pCI-HA.
- Des groupes de 6 souris BALB/c ont été immunisés à deux reprises à 4 semaines d’intervalle à l’aide de 2 Pg, 10Pg ou 50 Pg d’ADN plasmidique de pCI, pCI-S, pCI-S-CTE et pCI-S-WPRE.
Pour insister sur le fait que le virus actuel a été créé par la France, et qu’il est déjà connu depuis quelques années, le youtuber met en avant un paragraphe du brevet :
- [0223] Le sérum référencé au Centre National de Référence des virus influenzae (Région-Nord) sous le N° 20033168 est celui d’un patient français atteint d’une pneumopathie atypique causée par le SARS-CoV prélevé au jour 38 après le début des symptômes ; le diagnostic d’infection par le SARS-CoV a été réalisé par RT-PCR nichée et PCR quantitative (page 35)
- [0268] Les sérums de patients classés comme cas probables de SRAS de l’hôpital français de Hanoi, Vietnam ou en relation avec l’hôpital français de Hanoi (JYK) ont été analysés en utilisant le test IgG-N indirect et le test N double épitope.(page 40)
Pour finir, il avance l’hypothèse de l'existence potentielle d’un remède (déjà en 2017), et cite l'alinéa suivant du brevet :
- [0343] Enfin, les anticorps induits chez la souris après immunisation génique neutralisent l’infectivité du SRAS-CoV in vitro (figures 29A et 29B) à des titres qui sont en rapport avec les titres mesurés par ELISA (page 55)
Selon l’auteur, le Coronavirus a été crée et propagé par les inventeurs cités en couverture du brevet EP 1 694 829 B1 qu’il analyse dans la vidéo. Le seul but étant de susciter le besoin autour d’un remède déjà existant en sacrifiant des milliers de vies humaines.
Enfin, il précise que le vaccin qui sera disponible très rapidement sera très proche du vaccin de la rougeole.
Certains spécialistes crient au complot et mettent en garde les internautes
Pour certains spécialistes, le laboratoire P4 de Wuhan est faussement accusé car on oublie de rappeler que la coopération entre les Chinois et l’Institut Pasteur pour le développement de ce laboratoire ultra-sensible, a fait l’objet d’enquêtes minutieuses. Il s’agissait d’avoir des garanties concernant les normes de sécurité des installations et de s’assurer que Pékin n’utilise les équipements fournis à des fins offensives. Cette coopération a été lancée en 2004 du temps de Jacques Chirac, et le laboratoire a finalement été inauguré en 2017. S’agissant d’un domaine ultra-sensible, le fait que des enquêtes soient menées au préalable, était un passage obligé. Ce sont ces précautions que le récit conspirationniste fait passer pour les indices d’une « coopération sulfureuse » afin d’alimenter les soupçons.
L’argument des complotistes consiste aussi à dire : « Comme par hasard », c’est à Wuhan que se trouvent ces installations, et c’est là qu’explose le virus… En fait, il n'y a ni hasard ni coïncidence suspecte. Frédéric Keck, chercheur du CNRS, qui s’est lui-même rendu sur place pendant la construction du laboratoire, fournit des explications parfaitement rationnelles :
« La coïncidence entre l’émergence du coronavirus de Wuhan et la présence d’un laboratoire P4 à Wuhan s’explique par le fait que c’est dans cette région de Chine qu’émerge un grand nombre de nouveaux virus et que donc la France et la Chine ont souhaité être au plus près des lieux d’émergence pour pouvoir séquencer rapidement un nouveau virus au moment où il émerge et ainsi arrêter sa propagation. À chaque fois qu’un nouveau virus émerge, il y a ces rumeurs selon lesquelles il viendrait d’un laboratoire, mais c’est très difficile de fabriquer un nouveau virus et encore plus difficile de le relâcher sans en être la première victime. C’est la nature qui fabrique des nouveaux virus, ce ne sont pas les laboratoires. Et on voit maintenant que ce nouveau virus possède des séquences génétiques communes avec des virus de chauve-souris qui étaient connus depuis longtemps ».
Autrement dit, le raisonnement complotiste inverse la cause et l’effet, les ingénieurs de Wuhan en coopération avec des scientifiques du monde entier sont bel et bien engagés dans une course pour lutter contre le virus et pas le contraire.